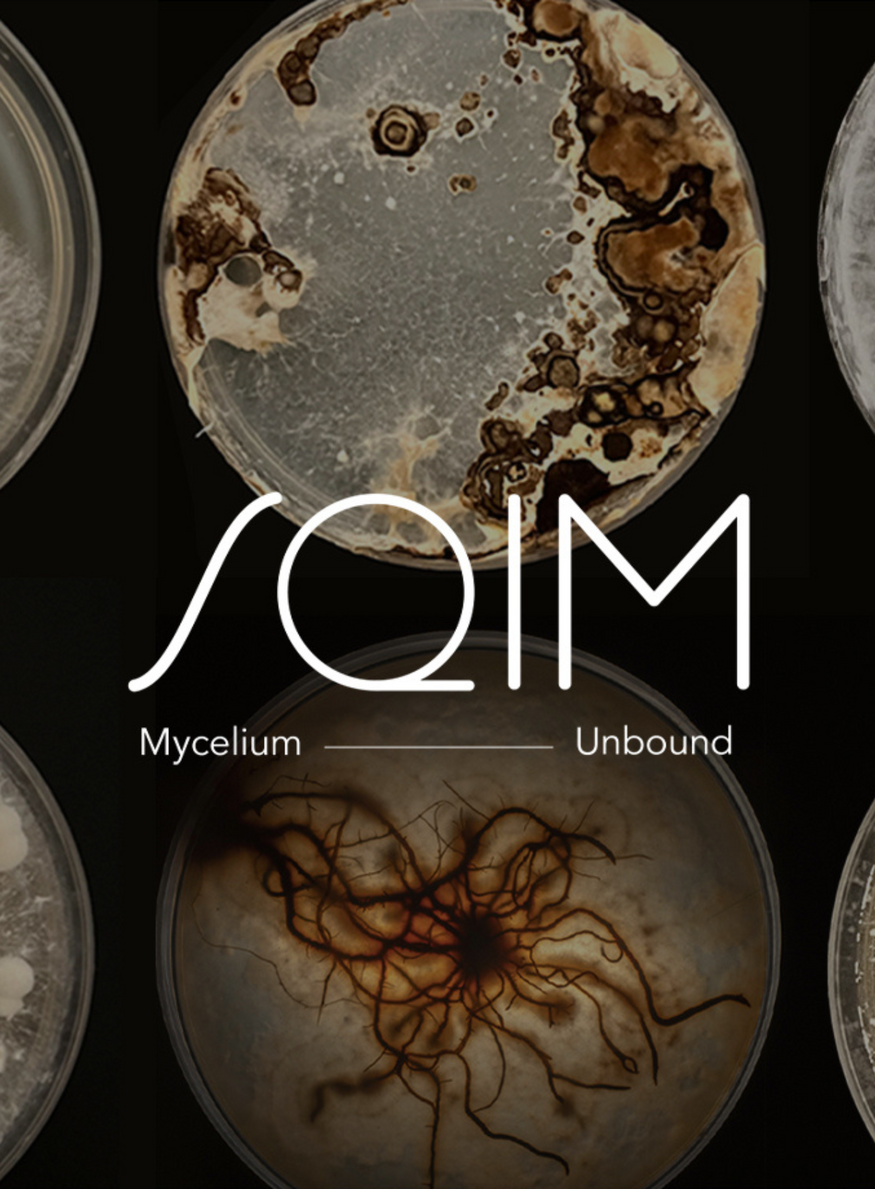

Kering soutient une start-up spécialisée dans les biomatériaux.
Publié le par Pauline Duvieu
Le géant du luxe a contribué, par sa société d'investissement Kering Ventures et aux côtés d'autres entreprises, à une levée de fonds de 11 millions d'euros pour la start-up SQIM, anciennement Mogu SRL. Cette somme permettra à la société de développer ses technologies basées sur le mycélium et s'adressant aux industries de la mode, de l'automobile et du design.
Vers une généralisation de l'utilisation du mycélium dans le luxe ?
Après avoir remporté le Prix de l'innovation 2023 de l'ANDAM pour son biomatériau Ephea, SQIM poursuit sa quête d'une industrie écoresponsable. La start-up créée en 2015 vient ainsi de lever 11 millions d'euros. Parmi les investisseurs, on trouve les entreprises CDP Venture Capital, ECBF VC, Progress Tech Transfer et Kering Ventures. Cette dernière n'est autre que la société d'investissement en capital-risque du groupe de luxe Kering. Sa vocation ? Acquérir des participations minoritaires dans les jeunes firmes, du digital à la culture en passant par l'environnement, tout en les connectant avec ses propres maisons et son réseau international.
Les 11 millions d'euros serviront à booster les activités de recherche et développement de SQIM, renforcer ses équipes et étendre la production industrielle à travers une usine dédiée à ses deux textiles green, Ephea et Mogu. Ces deux biomatériaux réalisés à partir de mycélium, la partie végétative des champignons, ont vocation à respectivement être utilisés dans la mode et l'automobile, et dans le design et l'architecture.
Ephea s'est déjà retrouvé sur le podium d'une des maisons de Kering pour la collection automne-hiver 2022-2023. Lors de la Fashion Week de Paris en mars 2022, Balenciaga avait ainsi présenté un manteau long noir réalisé dans ce biomatériau. Bien que récent, l'usage du mycélium n'est pas nouveau dans l'industrie textile. Après avoir dévoilé plusieurs prototypes de vêtement en 2021, Stella McCartney avait adopté l'alternative au cuir Mylo dans une série de sacs Frayme en édition limitée, lancée à l'été 2022.
Preuve qu'une production de ces matériaux novateurs, à plus ou moins grande échelle, n'est pas impossible et se concrétise à grand pas. D'autant plus si les start-up peuvent compter sur le soutien des acteurs du luxe, soucieux de développer de nouvelles matières écoresponsables et de répondre aux attentes durables de leurs consommateurs.